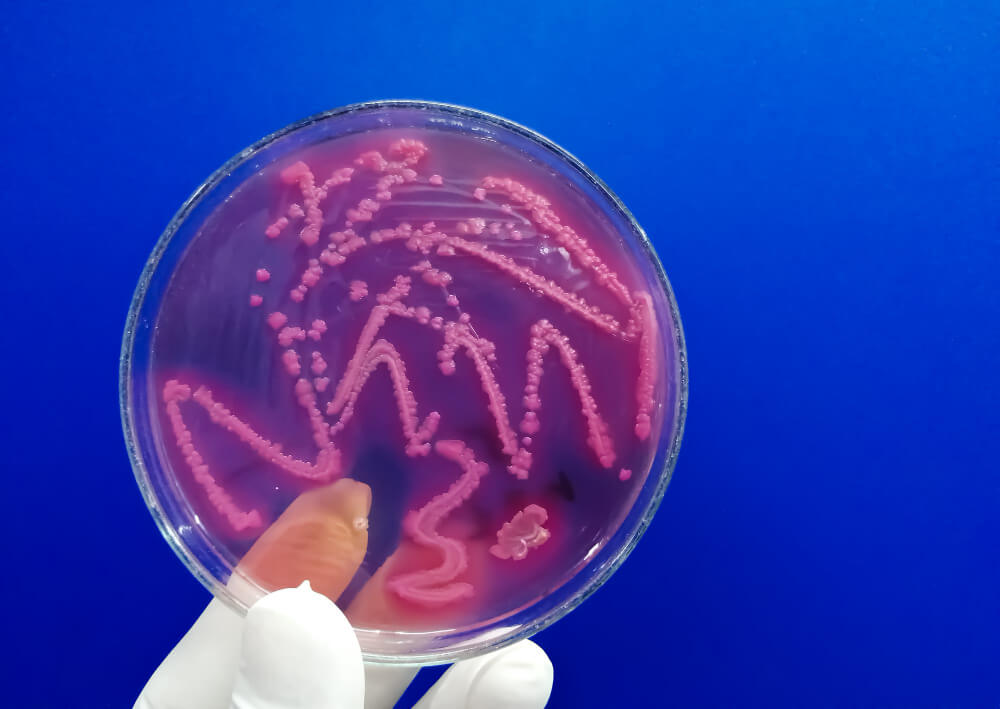
streptokok

Streptokok: Uzroci, simptomi i najbolji načini liječenja

Kada dijete počne žaliti se na bol u grlu i vrućicu, roditeljsko srce može postati puno zabrinutosti. Često se odmah pomisli na moguću bakterijsku infekciju, a ime streptokok može zvučati zastrašujuće. Međutim, znanje je najbolji saveznik.
Streptokok je, zapravo, rod gram-pozitivnih bakterija koji je široko rasprostranjen. Postoji više od 100 različitih vrsta ovih bakterija, a mnoge su potpuno bezopasne i dio su normalne flore našeg organizma.
Problem nastaje kada određeni sojevi izazovu upalu. Ova bakterija je jedan od najčešćih uzročnika upale grla, ali može dovesti i do drugih, ozbiljnijih zdravstvenih bolesti. Razumijevanje uzroka i simptoma ključno je za pravovremenu reakciju.
Ovaj članak će vas detaljno upoznati sa svim aspektima streptokoknih infekcija. Proći ćemo kroz načine prenošenja, karakteristične znakove bolesti, dijagnostičke postupke i učinkovite metode liječenja kako biste mogli djelovati s povjerenjem.
Ključni zaključci
- Streptokok je bakterija koja često izaziva zabrinutost, posebno kod roditelja.
- Postoji više od 100 vrsta streptokoka, a samo neke uzrokuju probleme.
- Ova bakterija je jedan od vodećih uzročnika upale grla.
- Razumijevanje simptoma pomaže u pravovremenom prepoznavanju infekcije.
- Pravilno liječenje ključno je za sprječavanje mogućih komplikacija.
- Mnoge vrste streptokoka bezopasne su i dio su normalne mikrobiote tijela.
Što je streptokok i zašto je važan?
Razumijevanje različitih vrsta streptokoka ključno je za pravilnu dijagnostiku i liječenje infekcija. Ove bakterije klasificiraju se prema svojim biokemijskim svojstvima, što pomaže kliničarima u odabiru optimalnog terapijskog pristupa.
Definicija i klasifikacija bakterija
Streptokoki su bakterije kuglastog oblika koje tvore lance. Osnovna podjela temelji se na njihovoj sposobnosti hemolize crvenih krvnih stanica.
Postoje tri glavne skupine: alfa-hemolitičke (djelomična razgradnja), beta-hemolitičke (potpuna hemoliza) i gama-hemolitičke (bez hemolize). Ova klasifikacija određuje patogeni potencijal različitih vrsta streptokoka.
Vrste streptokoka i njihove karakteristike
Najznačajnije skupine streptokoka su A i B. Streptokok skupine A uzrokuje upalu grla i kožne infekcije, dok je skupina B posebno opasna za novorođenčad.
Ostale vrste uključuju streptokoke skupina C i G (prijenos s životinja) te skupine D (probavni sustav). Alfa-hemolitički streptokoki, kao što je pneumokok, mogu izazvati upalu pluća.
Iako postoji više od 120 sojeva streptokoka, samo nekoliko vrsta redovito uzrokuje zdravstvene probleme. Poznavanje ovih skupina omogućuje ciljanu prevenciju i liječenje.
Klinička slika: simptomi i moguće komplikacije
Nagli početak bolesti često je prvi znak streptokokne infekcije. Karakteristični se simptomi razvijaju unutar 2–5 dana nakon izlaganja bakteriji.
Prepoznatljivi simptomi infekcije
Najčešći simptomi uključuju nagli porast temperature preko 38,5 °C i jaku bol u grlu koja otežava gutanje.
Grlo postaje izrazito crveno i otečeno. Na krajnicima se pojavljuju bijele ili žute gnojne naslage.
Limfni čvorovi na vratu su povećani i bolni. Ponekad se javljaju glavobolja, tresavica i opća slabost.
Šarlah se prepoznaje po crvenom osipu koji počinje na prsima. Jezik postaje upaljen i crven, a oko usta blijedo.
Erizipel zahvaća kožu s oštrim crvenilom. Zahvaćeno područje je toplo i bolno.
Komplikacije i teški oblici bolesti
Ako se infekcija ne liječi, mogu nastati ozbiljne komplikacije. Autoimuni odgovor može uzrokovati upalu bubrega.
Reumatska groznica je druga česta komplikacija. Ova bolest zahvaća srce i zglobove.
Sindrom toksičnog šoka rijetka je, ali opasna komplikacija. Praćen je niskim krvnim tlakom i zatajenjem organa.
Invazivna infekcija može izazvati meningitis ili sepsu. U teškim slučajevima dolazi do oštećenja tkiva.
Kod novorođenčadi infekcija može izazvati probleme s plućima i srcem. Pravodobno liječenje sprječava ove komplikacije.
Dijagnostika i testiranje: kako prepoznati infekciju
Liječnici koriste nekoliko metoda kako bi pouzdano identificirali uzročnika problema. Točna dijagnoza ključna je jer simptomi bakterijske infekcije često nalikuju onima virusnog podrijetla.
Postupak uključuje klinički pregled i laboratorijske analize. Svaki test ima svoje prednosti i specifičnu primjenu.
Brzi antigeni test i tehnike kultivacije
Brzi antigenski test daje rezultate za 10–15 minuta. Koristi obrisak ždrijela za otkrivanje streptokoka skupine A.
Kultivacija je zlatni standard. Uzgoj bakterija na hranjivoj podlozi traje nekoliko dana. Ova metoda omogućava identifikaciju vrste i testiranje osjetljivosti na antibiotike.
Molekularna dijagnostika i serološki pristup
Molekularne metode, kao što je PCR, otkrivaju genetski materijal. One su vrlo brze i osjetljive.
Serološka obrada traži protutijela u krvi. Manje je korisna za akutne infekcije jer se protutijela razvijaju sporije.
Važno je odrediti koncentraciju streptokoka. Mala količina (do 15%) često ukazuje na kliconoštvo.
Konzultacija s liječnikom nužna je za pravilno tumačenje nalaza. Pravilna dijagnoza sprječava nepotrebnu upotrebu antibiotika.
Liječenje streptokoknih infekcija: smjernice i terapijski pristupi
Pravilno liječenje streptokoknih infekcija zahtijeva precizan pristup temeljen na medicinskim smjernicama. Antibiotska terapija predstavlja ključnu liniju obrane, ne samo za uklanjanje bakterija već i za sprječavanje ozbiljnih komplikacija.
Antibiotska terapija i primjena penicilina
Penicilin je standardni lijek prvog izbora za infekcije uzrokovane skupinom A. Ova terapija standardno traje 10 dana kod upale grla.
Potpuno dovršavanje ciklusa od vitalne je važnosti. Čak i kada se simptomi povuku nakon nekoliko dana, prekid liječenja može dovesti do recidiva.
Alternativne opcije kod alergijskih reakcija
U slučajevima alergije na penicilin, liječnici propisuju alternative. Koriste se makrolidni antibiotici kao što su azitromicin ili eritromicin.
Teži slučajevi zahtijevaju hospitalizaciju. Intravenska primjena lijekova nužna je kod invazivnih oblika infekcije.
Pravilna primjena antibiotika sprječava razvoj rezistencije. Svaki plan liječenja treba prilagoditi specifičnoj infekciji i pacijentu.
Prevencija i zaštita: kako spriječiti širenje infekcija
Kontrola streptokoknih infekcija počinje razumijevanjem načina prijenosa. Ove bakterije najčešće se šire kapljičnim putem tijekom govora, kašljanja ili kihanja. Izravan kontakt s kožom zaražene osobe također predstavlja rizik.
Prijenos može biti posredovan i kontaminiranim predmetima. Ručnici, posteljina i igračke mogu prenositi uzročnike. Stoga je važno izbjegavati dijeljenje osobnih predmeta.
Preventivne higijenske mjere
Temeljito pranje ruku najvažnija je zaštitna mjera. Redovito korištenje sapuna i vode uništava uzročnike. Ova jednostavna navika sprječava širenje infekcije.
Pokrivanje usta prilikom kašljanja smanjuje raspršivanje bakterija. Izbjegavanje bliskog kontakta s oboljelim osobama također je ključno. Održavanje čistoće prostora dodatno smanjuje rizik.
Profilaktička terapija i briga u trudnoći
Posebnu pažnju zahtijevaju trudnice kod kojih se provodi probir na streptokok skupine B. Testiranje se obavlja između 35. i 37. tjedna trudnoće. Vaginalni i rektalni obrisak omogućuju detekciju.
Kod pozitivnog nalaza primjenjuje se profilaktička antibiotska terapija. Ovaj pristup smanjio je neonatalne infekcije za gotovo 80%. Pravovremena intervencija štiti novorođenčad.
Važno je napomenuti da kliconoštvo otežava kontrolu širenja. Oko 5–15% ljudi nosi piogeni streptokok bez simptoma. Stoga su preventivne mjere od posebne važnosti.
Streptokoke kod djece i odraslih: specifičnosti po dobnim skupinama
Rizik od streptokokne infekcije varira kroz životni vijek, s najvećom učestalošću u školskoj dobi. Djeca između 5 i 15 godina posebno su osjetljiva na ove bakterije.
Infekcije u dječjim kolektivima
Zatvoreni prostori poput vrtića i škola pogoduju širenju streptokoknih infekcija. Bliski kontakt omogućava lak prijenos kapljičnim putem.
Dječaci pokazuju nešto veću sklonost ovim infekcijama od djevojčica. Dva vršna perioda javljanja su oko 6. i 13. godine života.
Kod mlađe djece česte su kožne infekcije, posebno ljeti. Zimi dominiraju upale grla i respiratorni problemi.
Posebnosti infekcija kod odraslih
Odrasle osobe razvijaju zaštitna IgG protutijela kroz život. Ova imunost smanjuje učestalost streptokoknih infekcija.
Ipak, određene skupine ostaju ranjive. Starije osobe iznad 75 godina i ljudi s kroničnim bolestima trebaju posebnu pažnju.
Novorođenčad do mjesec dana izuzetno je osjetljiva na streptokok skupine B. Pravovremeno testiranje trudnica sprječava ozbiljne komplikacije.
Posebne forme streptokoknih infekcija
Osim klasične upale grla, streptokok se može manifestirati kroz nekoliko karakterističnih kliničkih slika. Svaka forma ima specifične simptome koji zahtijevaju različite pristupe liječenju.
Gnojna angina i streptokokna upala grla
Streptokokna upala grla, poznata kao gnojna angina, predstavlja najčešći oblik infekcije. Karakterizira je nagli početak s temperaturom preko 38,5 °C i jakom boli pri gutanju.
Grlo postaje izrazito crveno i otečeno. Na krajnicima se pojavljuju bijele ili žute gnojne naslage. Limfni čvorovi na vratu su povećani i bolni na dodir.
Šarlah, erizipel i invazivne infekcije
Šarlah se prepoznaje po crvenom osipu koji počinje na prsima i trbuhu. Jezik postaje upaljen i crven, a oko usta blijedo. Ova streptokokna upala praćena je visokom temperaturom.
Erizipel zahvaća gornji sloj kože i potkožno limfno tkivo. Zahvaćeno područje je oštro ograničeno, crveno, toplo i bolno. Često se javljaju vrućica i umor.
Invazivne upale nastaju kada bakterija uđe u krvotok. Mogu izazvati meningitis ili sepsu. Nekrotizirajući fascitis rijetka je forma s propadanjem tkiva koja zahtijeva hitno kirurško liječenje.
Epidemiologija i trendovi: što nam govori vrijeme
Epidemiološki podaci pružaju važan uvid u širenje streptokoknih infekcija kroz različita godišnja doba. Ove bolesti pokazuju jasne sezonske obrasce koji pomažu u planiranju preventivnih mjera.
Sezonske varijacije i populacijski rizici
Streptokokne infekcije skupine A imaju vršni period tijekom zime i ranog proljeća. Ovo se objašnjava većim boravkom osoba u zatvorenim prostorima.
Kolonizacija streptokokom skupine B prisutna je kod oko 25% žena. Ove infekcije često prolaze bez simptoma, ali mogu biti opasne za novorođenčad.
U Europi se neonatalna streptokokna bolest javlja u 0,5–3,7 slučajeva na 1000 živorođenih. Ovo predstavlja značajan javnozdravstveni problem.
Utjecaj pandemije i povratak u kolektive
Početkom 2023. godine zabilježeno je povećanje pojavnosti streptokoknih infekcija kod djece. Ovo se posebno vidjelo u Hrvatskoj i drugim zemljama.
Povratak u školske kolektive nakon COVID-19 izolacije može dovesti do bržeg širenja bakterija. Imunološki sustav djece bio je manje izložen uobičajenim patogenima.
Zabrinjava povećanje invazivnih oblika streptokokne bolesti. Ovi teški slučajevi zahtijevaju hitnu medicinsku pomoć.
Globalno, piogeni streptokok uzrokuje više od 500 000 smrtnih slučajeva godišnje. To naglašava ozbiljnost ovih bolesti.
Zaključak
Unatoč širokoj rasprostranjenosti streptokoknih bakterija, suvremena medicina ima učinkovite alate za njihovu kontrolu. Rano prepoznavanje simptoma i pravovremena dijagnostika ključni su za sprječavanje ozbiljnih komplikacija.
Većina infekcija danas se uspješno liječi antibioticima. Penicilin ostaje standardni izbor, a kod alergija koriste se alternativni lijekovi. Pravilno liječenje sprječava razvoj teških bolesti, kao što su reumatska groznica.
Probir trudnica na streptokok skupine B i profilaktička terapija smanjili su neonatalne infekcije za 80%. Ovo je jedan od najvećih uspjeha u borbi protiv ovih bolesti.
Iako cjepiva još nisu dostupna, istraživanja napreduju. Povećanje svijesti o ovim komplikacijama može zaštititi najugroženije skupine. Različite skupine streptokoka zahtijevaju različite pristupe.
Česta pitanja
Koji su najčešći simptomi streptokokne upale grla?
Najuočljiviji znakovi uključuju jake bolove u grlu, poteškoće s gutanjem, visoku temperaturu te povećane i bolne žlijezde na vratu. Često se javlja i crvenilo krajnika s bjelkastim ili žućkastim naslagama. Za razliku od virusnih upala, obično nema kašlja ili curenja iz nosa.
Kako se prenosi ova bakterija i koliko je zarazna?
Prijenos se događa kapljičnim putem, prilikom udisanja zraka s kapljicama iz kašlja ili kihanja zaražene osobe. Zaraženi može prenositi bakteriju i nekoliko dana prije pojave prvih simptoma. Direktan kontakt s predmetima kontaminiranim sekretima iz nosa ili grla također predstavlja rizik.
Koje komplikacije mogu nastati ako se infekcija ne liječi?
Neliječena infekcija može dovesti do ozbiljnih zdravstvenih problema. To uključuje reumatsku groznicu, koja može oštetiti srčane zaliske, te poststreptokokni glomerulonefritis, vrstu upale bubrega. Gnojne komplikacije poput apscesa krajnika također su moguće.
Koji je najpouzdaniji test za dijagnozu?
Zlatni standard je uzgoj bakterije iz briseva grla, koji daje konačan rezultat. Međutim, brzi test antigena često se koristi u ordinacijama jer daje rezultat za nekoliko minuta. U slučaju negativnog brzog testa, a prisutnih jakih simptoma, liječnik će obično poslati bris na kultivaciju.
Je li penicilin i dalje učinkovit za liječenje?
Da, penicilin ostaje lijek prvog izbora za liječenje streptokokne upale grla jer je bakterija rijetko rezistentna na njega. Terapija traje obično 10 dana kako bi se osiguralo potpuno iskorjenjivanje bakterije i spriječile komplikacije. Kod alergije na penicilin koriste se drugi antibiotici.
Kako se možemo zaštititi od širenja bolesti u obitelji?
Ključne mjere uključuju često pranje ruku sapunom i vodom, izbjegavanje dijeljenja posuđa i pribora za jelo te pravilno odlaganje maramica nakon korištenja. Zaražena osoba trebala bi ostati kod kuće i izbjegavati bliski kontakt s drugima barem 24 sata nakon početka uzimanja antibiotika.
Zašto su djeca češće zaražena od odraslih?
Djeca su osjetljivija jer se njihov imunološki sustav još uvijek razvija i prvi put se susreću s ovom bakterijom. Bliski kontakt u vrtićima i školama, gdje se igraju i dijele igračke, znatno povećava mogućnost prijenosa. Odrasli su često izgradili određeni imunitet kroz prethodne blage izloženosti.
Izvori:
- Begovac, J., Božinović, D., Lisić, M. i Babudieri, S. (2006). Infektologija (drugo, dopunjeno izdanje). Profil International, Zagreb, odabrana poglavlja.
- Kaić, B., Guzvinec, M. i Aleraj, B. (2015). Streptokokne infekcije skupine A – epidemiološki nadzor i prevencija. Hrvatski časopis za javno zdravstvo, 11(42), 25-32.



